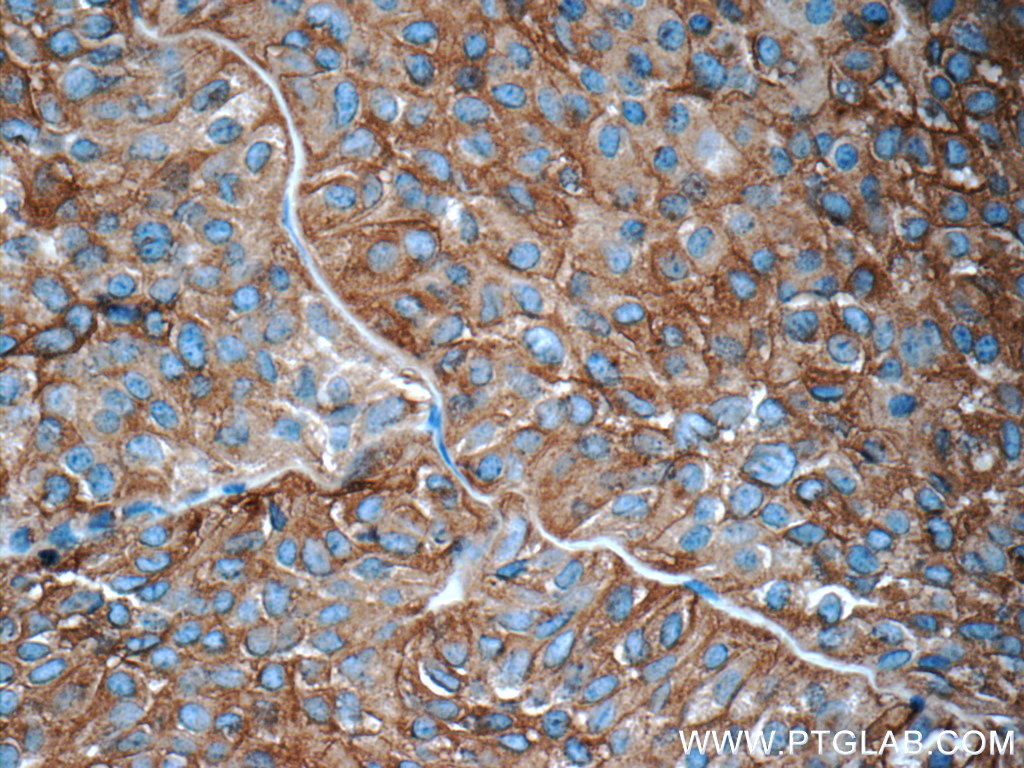

验证数据展示
经过测试的应用
| Positive WB detected in | mouse brain tissue, PC-12 cells, SH-SY5Y cells, rat brain tissue, mouse cerebellum tissue, rat cerebellum tissue |
| Positive IP detected in | mouse brain tissue |
| Positive IHC detected in | mouse pancreas tissue, mouse brain tissue, human brain tissue, ganglioma tissue, human pancreas tissue, neuroblastoma tissue, human pituitary adenoma tissue Note: suggested antigen retrieval with TE buffer pH 9.0; (*) Alternatively, antigen retrieval may be performed with citrate buffer pH 6.0 |
| Positive IF-P detected in | mouse pancreas tissue, human gliomas tissue, mouse brain tissue |
推荐稀释比
| 应用 | 推荐稀释比 |
|---|---|
| Western Blot (WB) | WB : 1:20000-1:100000 |
| Immunoprecipitation (IP) | IP : 0.5-4.0 ug for 1.0-3.0 mg of total protein lysate |
| Immunohistochemistry (IHC) | IHC : 1:1000-1:4000 |
| Immunofluorescence (IF)-P | IF-P : 1:50-1:500 |
| It is recommended that this reagent should be titrated in each testing system to obtain optimal results. | |
| Sample-dependent, Check data in validation data gallery. | |
产品信息
17785-1-AP targets Synaptophysin in WB, IHC, IF-P, IP, ELISA applications and shows reactivity with human, mouse, rat samples.
| 经测试应用 | WB, IHC, IF-P, IP, ELISA Application Description |
| 文献引用应用 | WB, IHC, IF |
| 经测试反应性 | human, mouse, rat |
| 文献引用反应性 | human, mouse, rat, canine, zebrafish, hamster |
| 免疫原 |
CatNo: Ag11781 Product name: Recombinant human Synaptophysin; SYP protein Source: e coli.-derived, PGEX-4T Tag: GST Domain: 50-313 aa of BC064550 Sequence: ELQLSVDCANKTESDLSIEVEFEYPFRLHQVYFDAPTCRGGTTKVFLVGDYSSSAEFFVTVAVFAFLYSMGALATYIFLQNKYRENNKGPMLDFLATAVFAFMWLVSSSAWAKGLSDVKMATDPENIIKEMPVCRQTGNTCKELRDLVTSGLNTSVVFGFLNLVLWVGNLWFVFKETGWAAPFLRAPPGAPEKQPAPGDAYGDAGYGQGPGGYGPQDSYGPQGGYQPDYGQPAGSGGSGYGPQGDYGQQGYGPQGAPTSFSNQM 种属同源性预测 |
| 宿主/亚型 | Rabbit / IgG |
| 抗体类别 | Polyclonal |
| 产品类型 | Antibody |
| 全称 | synaptophysin |
| 别名 | SYP, MRX96, SYN |
| 计算分子量 | 313 aa, 34 kDa |
| 观测分子量 | 38-40 kDa |
| GenBank蛋白编号 | BC064550 |
| 基因名称 | Synaptophysin |
| Gene ID (NCBI) | 6855 |
| RRID | AB_2271365 |
| 偶联类型 | Unconjugated |
| 形式 | Liquid |
| 纯化方式 | Antigen affinity purification |
| UNIPROT ID | P08247 |
| 储存缓冲液 | PBS with 0.02% sodium azide and 50% glycerol, pH 7.3. |
| 储存条件 | Store at -20°C. Stable for one year after shipment. Aliquoting is unnecessary for -20oC storage. |
背景介绍
Synaptophysin (SYP, also known as major synaptic vesicle protein p38) is a 38-kDa integral membrane glycoprotein that regulates synaptic vesicle endocytosis. It is the most abundant synaptic vesicle protein by mass. Synaptophysin is present in neuroendocrine cells and neurons that participate in synaptic transmission. Synaptophysin is a useful marker for the identification of neuroendocrine cells and neoplasms. Synaptic proteins, including synaptophysin, are reduced in brain tissue from patients with Alzheimer's disease. (PMID: 3010302; 21658579)
实验方案
| Product Specific Protocols | |
|---|---|
| IF protocol for Synaptophysin antibody 17785-1-AP | Download protocol |
| IHC protocol for Synaptophysin antibody 17785-1-AP | Download protocol |
| IP protocol for Synaptophysin antibody 17785-1-AP | Download protocol |
| WB protocol for Synaptophysin antibody 17785-1-AP | Download protocol |
| Standard Protocols | |
|---|---|
| Click here to view our Standard Protocols |
发表文章
| Species | Application | Title |
|---|---|---|
Signal Transduct Target Ther Single-cell RNA-seq reveals cell type-specific molecular and genetic associations with primary open-angle glaucoma | ||
Nat Biotechnol Magnify is a universal molecular anchoring strategy for expansion microscopy | ||
Nat Neurosci Aerobic glycolysis is the predominant means of glucose metabolism in neuronal somata, which protects against oxidative damage | ||
Mol Cell Mixed Lineage Kinase Domain-like Protein MLKL Breaks Down Myelin following Nerve Injury. | ||
Neuron Astrocytic ApoE reprograms neuronal cholesterol metabolism and histone-acetylation-mediated memory. |